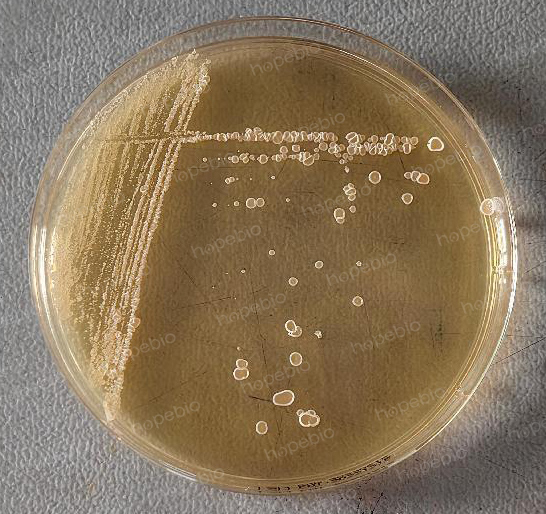

海博微信公众号
海博微信公众号
 海博天猫旗舰店
海博天猫旗舰店


 海博微信公众号
海博微信公众号
 海博天猫旗舰店
海博天猫旗舰店




一、用途:
二、检验方法:
称取本品37.58g,加热溶解于1000ml蒸馏水中,分装,121℃高压灭菌15分钟,备用。
注:培养基中含柠檬酸铁铵,灭菌后可能出现微量沉淀。
三、质控结果:
按标签用法制备培养基,接种以下质控菌株,放置28℃需氧培养48-96小时。
|
质控菌株 |
菌株编号 |
接种量(CFU) |
生长情况 |
其他特征 |
|
白色链霉菌 |
ATCC 12757 |
/ |
+++ |
生长良好 |
相关产品:
下一篇:没有了!



